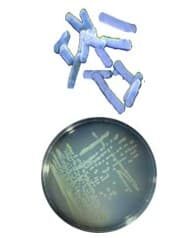
artrik-7298025
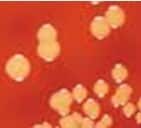
micrococcus-denitrificans-1317804

Ciri Ciri Bakteri : Klasifikasi, Struktur, Bentuk, & Macam – Bakteri merupakan organisme yang paling banyak jumlahnya dan lebih tersebar luas dibandingkan mahluk hidup yang lain. Bakteri memiliki ratusan ribu spesies yang hidup di darat hingga lautan dan pada tempat-tempat yang ekstrim.

Bakteri ada yang menguntungkan tetapi ada pula yang merugikan. Bakteri memiliki ciri-ciri yang membedakannya dengan mahluk hidup yang lain. Bakteri adalah organisme uniselluler dan prokariot serta umumnya tidak memiliki klorofil dan berukuran renik (mikroskopis).
Baca Juga Artikel Yang Mungkin Berhubungan : Jaringan Tumbuhan [LENGKAP] : Pengertian, Ciri, Macam Dan Fungsi
Pengertian Bakteri
Bakteri, berasal dari kata Latin, bacterium (jamak, bacteria); adalah kelompok raksasa dari organisme hidup. Mereka sangatlah kecil (mikroskopik) dan kebanyakan uniselular (bersel tunggal), dengan struktur sel yang relatif sederhana tanpa nukleus/inti sel, sitoskeleton, dan organel lain seperti mitokondria dan kloroplas. Struktur sel mereka dijelaskan lebih lanjut dalam artikel mengenai prokariota, karena bakteri merupakan prokariota, untuk membedakan mereka dengan organisme yang memiliki sel lebih kompleks, disebut eukariota. Istilah “bakteri” telah diterapkan untuk semua prokariota atau untuk kelompok besar mereka, tergantung pada gagasan mengenai hubungan mereka.
Bakteri adalah yang paling berkelimpahan dari semua organisme. Mereka tersebar (berada di mana-mana) di tanah, air, dan sebagai simbiosis dari organisme lain. Banyak patogen merupakan bakteri. Kebanyakan dari mereka kecil, biasanya hanya berukuran 0,5-5 μm, meski ada jenis dapat menjangkau 0,3 mm dalam diameter (Thiomargarita). Mereka umumnya memiliki dinding sel, seperti sel hewan dan jamur, tetapi dengan komposisi sangat berbeda (peptidoglikan). Banyak yang bergerak menggunakan flagela yang berbeda dalam strukturnya dari flagela kelompok lain.
Baca Yang Mungkin Berhubungan : Kingdom Protista : Mirip Jamur, Hewan, Tumbuhan, Dan Ciri Juga Klasifikasinya
CIRI CIRI BAKTERI
Bakteri memiliki ciri-ciri yang membedakannnya dengan mahluk hidup lain yaitu :
- Organisme multiselluler.
- Prokariot (tidak memiliki membran inti sel ).
- Umumnya tidak memiliki klorofil.
- Memiliki ukuran tubuh yang bervariasi antara 0,12 s/d ratusan mikron umumnya memiliki ukuran rata-rata 1 s/d 5 mikron.
- Memiliki bentuk tubuh yang beraneka ragam.
- Hidup bebas atau parasit.
- Yang hidup di lingkungan ekstrim seperti pada mata air panas,kawah atau gambut dinding selnya tidak mengandung peptidoglikan.
- Yang hidupnya kosmopolit diberbagai lingkungan dinding selnya mengandung peptidoglikan.
- Ciri umum bakteri yang pertama, mereka adalah Organisme prokariota (inti sel tidak diselimuti membran khusus) juga uniseluler (atau bersel tunggal)
- Bakteri memiliki dinding sel seperti tumbuhan yang tersusun atau peptidoglikan dan mukopolisakarida.
- Bakteri mamiliki endospora yaitu kapsul yang muncul jika kondisi yang tidak menguntungkan sebagai perisai terhadap panas dan gangguan alam.
- Dari segi ukuran, bakteri pada umumnya bakteri terlalu kecil seperti Mycoplasma untuk dilihat mata telanjang yakni sekitar 0,5 mikrometer tapi dan ada juga yang sedikit lebih besar yakni Epulopiscium fishelsoni mencapai ukuran yaitu sekitar 10-100 mikrometer.
- Ciri umum lainnya dari bakteri hidup adalah mereka makhluk yang parasit (membutuhkan inang seperti manusia atau hewan) tapi ada juga yang hidup bebas.
- Secara umum bakteri tidak berklorofil.
- Habitat bakteri dapat tinggal dilingkungan yang keras seperti air panas, kawah, gambut.
- Dilihat dari bentuk penampakan, sel bakteri bisa terlihat seperti basil (atau batang), kokus (berbentuk bola), spirilum (spiral seperti pembuka tutup botol), kokobasil (bulat dan batang), dan Vibrio (seperti koma).
Sebagai bagian dari perlindungan, bakteri dapat mensekresikan lendir ke permukaan dinding sel. 8-10 % fosfolipid dan protein adalah penyusun membran sitoplasma dan bakteri. Bakteri ada yang memiliki ekor juga disebut dengan flagela untuk bergerak sedangkan bakteri yang tidak memiliki flagela bergerak dengan cara seperti berguling (Rosihan, 2015).
Baca Juga Artikel Yang Mungkin Berhubungan : Kingdom Animalia : Pengertian, Ciri, Dan Klasifikasi Beserta Contohnya Lengkap
KLASIFIKASI BAKTERI
Klasifikasi Dan Nama Nama Bakteri Beserta Gambar BERDASARKAN JUMLAH DAN KEDUDUKAN FLAGELLA
| No | Klasifikasi | Nama bakteri | Gambar | Keterangan |
| 1 | Artrik | – Clostridium tetani
– Escherichia coly |
|
Bakteri yang tidak mempunyai flagellum. Bakteri ini terdapat di usus besar manusia dan dapat menyebabkan keracunan. |
| 2 | Monotrik | Vibrio cholerae | 
|
Bakteri yang mempunyai flagellum pada salah satu dinding selnya. Bakteri ini penyebab penyakit kolera |
| 3 | Lopotrik
|
– Rhodospirillum rubrum
– Spirillumminor |

|
Bakteri yang mempunyai flagellum pada kedua dinding selnya. |
| 4 | Peritrik | Methano bacterium | 
|
Memiliki flagellum diseluruh permukaan Bakteri. Bakteri ini adalah bakteri yang hidup dilingkungkan dengan kadar garam tinggi |
| 5 | Amfitrik
|
Nitrosomonas
dan Nitrosococcus |

|
Memiliki dua atau lebih flagellum dikedua ujung sel Bakteri dan menjadi penyebab penyakit pada tanaman dan hjewan |
Baca Juga Artikel Yang Mungkin Berhubungan : Jaringan Meristem : Pengertian, Jenis, Ciri Dan Contohnya [LENGKAP]
Klasifikasi Dan Nama Nama Bakteri Beserta Gambar BERDASAKAN CARA MEMPEROLEH ENERGI
| No | Klasifikasi | Nama bakteri | Gambar | Keterangan |
| 1 | Bakteri aerob | Nitrosococcus
. |

|
Bakteri yang memiliki metabolisme berbasis oksigen. berperan dalam proses penambahan kesuburan tanah (membentuk humus). |
| Nitrosomonas | 
|
sebuah bakteri berbentuk batang yang terdiri dari genus chemoautotrophic. berperan dalam proses nitrifikasi menghasilkan ion nitrat yang dibutuhkan tanaman | ||
| 2 | Bakteri anaerob | Clostridium tetani (anaerob obligat)
|

|
bakteri Gram positif, anaerob obligat, dapat membentuk spora, dan berbentuk drumstick. Bakteri ini menyebabkan penyakit Tetanus |
| Shigella (anaerob fakultatif) |
|
Mengubah Nitrit Menjadi Nitrat 3 Rhizobium Menambat Nitrogen | ||
| Escherichia coli (anaerob fakultatif)
|

|
alah satu jenis spesies utama bakteri gram negatif
ditemukan dalam usus besar manusia |
||
| Salmonella (anaerob fakultatif)
|
|
suatu genus bakteri enterobakteria gram-negatif berbentuk tongkat yang menyebabkan tifus, paratifus, dan penyakit foodborne |
Baca Juga Artikel Yang Mungkin Berhubungan : Kingdom Plantae : Pengertian, Ciri, Klasifikasi, Jenis Dan Contohnya Lengkap
Klasifikasi Dan Nama Nama Bakteri Beserta Gambar BERDASARKAN BENTUKNYA
Baca Juga Artikel Yang Mungkin Berhubungan : Kingdom Monera : Ciri, Contoh, Gambar, Struktur, Klasifikasi
Klasifikasi Dan Nama Nama Bakteri Beserta Gambar BERDASARKAN KETAHANAN SUHU
| No | Klasifikasi | Nama Bakteri | Gambar | Keterangan |
| 1 | Bakteri Psikrofil | bakteri besi (Gallionella) | 
|
bakteri yang hidup pada daerah suhu rendah antara 0°– 30 °C, dengan suhu optimum 15 °C. bakteri ini banyak terdapat didasar lautan dan daerah kutub. |
| 2 | Bakteri Mesofil | micrococcus Denitrificans |
|
bakteri yang hidup dan tumbuh di daerah suhu antara 15°- 55°C, dengan suhu optimum 25°- 40°C.
Bakteri ini Yang Menyebabkan Denitrifikasi |
| 3 | Bakteri Termofil | Clostridium thermo saccha | 
|
Bakteri yang dapat hidup dan tumbuh di daerah suhu tinggi antara 45° – 75°C,
bakteri ini dapat ditemukan ditempat bersuhu tinggi. |
| 4 | Bakteri Hipertermofil | Bacillus
|

|
Merupakan Bakteri yang dapat hidup dan tumbuh pada suhu diatas 75°C, beberapa bakteri ini bahkan dapat hidup pada suhu diatas 100°C dan dapat menghasilkan enzim-enzim penting yang digunakan dalam obat-obatan |
Baca Juga Artikel Yang Mungkin Berhubungan : Jaringan Ikat : Pengertian, Materi Lengkap, Fungsi, Komponen Dan Jenisnya
Klasifikasi Dan Nama Nama Bakteri Beserta Gambar BERDASARKAN CARA HIDUPNYA/ MENDAPAT MAKANAN
Baca Juga Artikel Yang Mungkin Berhubungan : Kingdom Fungi/Jamur : Klasifikasi Jamur, Pengertian, Contoh, Struktur
STRUKTUR BAKTERI
Struktur bakteri terbagi menjadi dua yaitu:
- Struktur dasar (dimiliki oleh hampir semua jenis bakteri)
Meliputi: dinding sel, membran plasma, sitoplasma, ribosom, DNA, dan granula penyimpanan
- Struktur tambahan (dimiliki oleh jenis bakteri tertentu)
Meliputi kapsul, flagelum, pilus, fimbria, klorosom, Vakuola gas dan endospora.

Struktur Tubuh bakteri
- Dinding sel tersusun dari peptidoglikan yaitu gabungan protein dan polisakarida (ketebalan peptidoglikan membagi bakteri menjadi bakteri gram positif bila peptidoglikannya tebal dan bakteri gram negatif bila peptidoglikannya tipis).
- Membran plasma adalah membran yang menyelubungi sitoplasma tersusun atas lapisan fosfolipid dan protein.

- Sitoplasma adalah cairan sel.
- Ribosom adalah organel yang tersebar dalam sitoplasma, tersusun atas protein dan RNA.
- Granula penyimpanan, karena bakteri menyimpan cadangan makanan yang dibutuhkan.

Struktur tambahan bakteri
- Kapsul atau lapisan lendir adalah lapisan di luar dinding sel pada jenis bakteri tertentu, bila lapisannya tebal disebut kapsul dan bila lapisannya tipis disebut lapisan lendir. Kapsul dan lapisan lendir tersusun atas polisakarida dan air.
- Flagelum atau bulu cambuk adalah struktur berbentuk batang atau spiral yang menonjol dari dinding sel.

- Pilus dan fimbria adalah struktur berbentuk seperti rambut halus yang menonjol dari dinding sel, pilus mirip dengan flagelum tetapi lebih pendek, kaku dan berdiameter lebih kecil dan tersusun dari protein dan hanya terdapat pada bakteri gram negatif. Fimbria adalah struktur sejenis pilus tetapi lebih pendek daripada pilus.

- Klorosom adalah struktur yang berada tepat dibawah membran plasma dan mengandung pigmen klorofil dan pigmen lainnya untuk proses fotosintesis. Klorosom hanya terdapat pada bakteri yang melakukan fotosintesis.
- Vakuola gas terdapat pada bakteri yang hidup di air dan berfotosintesis.
- Endospora adalah bentuk istirahat (laten) dari beberapa jenis bakteri gram positif dan terbentuk didalam sel bakteri jika kondisi tidak menguntungkan bagi kehidupan bakteri. Endospora mengandung sedikit sitoplasma, materi genetik, dan ribosom. Dinding endospora yang tebal tersusun atas protein dan menyebabkan endospora tahan terhadap kekeringan, radiasi cahaya, suhu tinggi dan zat kimia. Jika kondisi lingkungan menguntungkan endospora akan tumbuh menjadi sel bakteri baru.

Baca Juga Artikel Yang Mungkin Berhubungan : Jaringan Hewan : Jenis, Fungsi, Letak, Gambar Dan Contohnya
Bentuk Bakteri
- Bentuk dasar bakteri terdiri atas
- bentuk bulat (kokus),
- batang (basil), dan
- spiral (spirilia) serta terdapat bentuk antara kokus dan basil yang disebut kokobasil.
Berbagai macam bentuk bakteri :
Bakteri Kokus

- Monokokus yaitu berupa sel bakteri kokus tunggal.
- Diplokokus yaitu dua sel bakteri kokus berdempetan.
- Tetrakokus yaitu empat sel bakteri kokus berdempetan berbentuk segi empat.
- Sarkina yaitu delapan sel bakteri kokus berdempetan membentuk kubus
- Streptokokus yaitu lebih dari empat sel bakteri kokus berdempetan membentuk rantai.
- Stapilokokus yaitu lebih dari empat sel bakteri kokus berdempetan seperti buah anggur
Bakteri Basil

- Monobasil yaitu berupa sel bakteri basil tunggal
- Diplobasil yaitu berupa dua sel bakteri basil berdempetan
- Streptobasil yaitu beberapa sel bakteri basil berdempetan membentuk rantai
Bakteri Spirilia

- Spiral yaitu bentuk sel bergelombang
- Spiroseta yaitu bentuk sel seperti sekrup
- Vibrio yaitu bentuk sel seperti tanda baca koma.
Cara Perkembangbiakan bakteri
Bakteri umumnya melakukan reproduksi atau berkembang biak secara aseksual (vegetatif = tak kawin) dengan membelah diri. Pembelahan sel pada bakteri adalah pembelahan biner yaitu setiap sel membelah menjadi dua. Reproduksi bakteri secara seksual yaitu dengan pertukaran materi genetik dengan bakteri lainnya. Pertukaran materi genetik disebut rekombinasi genetik atau rekombinasi DNA.
Rekombinasi genetik dapat dilakukan dengan tiga cara yaitu :
- Transformasi adalah pemindahan sedikit materi genetik, bahkan satu gen saja dari satu sel bakteri ke sel bakteri yang lainnya.
- Transduksi adalah pemindahan materi genetik satu sel bakteri ke sel bakteri lainnnya dengan perantaraan organisme yang lain yaitu bakteriofage (virus bakteri).
- Konjugasi adalah pemindahan materi genetik berupa plasmid secara langsung melalui kontak sel dengan membentuk struktur seperti jembatan diantara dua sel bakteri yang berdekatan. Umumnya terjadi pada bakteri gram negatif.
Bentuk Tubuh Bakteri
Bentuk tubuh bakteri dipengaruhi oleh keadaan lingkungan, medium dan usia. Oleh karena itu untuk membandingkan bentuk serta ukuran bakteri, kondisinya harus sama. Pada umumnya bakteri yang usianya lebih muda ukurannya relatif lebih besar daripada yang sudah tua.
SIFAT BAKTERI
- Inti sel tidak berdinding yang disebut prokarion.
- Berkembang biak Dengan Membelah Diri.
- Beberapa Jenis bakteri terutama Yang Berbentuk Batang dapat membentuk endospora. Yang Berguna Untuk Melindungi Diri Terhadap Lingkungan Yang Buruk.
- Bakteri Pada Suhu Yang Bervariasi Dan pH tertentu sesuai dengan jenisnya.
ALAT GERAK BAKTERI
Alat gerak pada bakteri berupa flagellum atau bulu cambuk adalah struktur berbentuk batang atau spiral yang menonjol dari dinding sel. Flagellum memungkinkan bakteri bergerak menuju kondisi lingkungan yang menguntungkan dan menghindar dari lingkungan yang merugikan bagi kehidupannya.
Flagellum memiliki jumlah yang berbeda-beda pada bakteri dan letak yang berbeda-beda pula yaitu
- Monotrik : bila hanya berjumlah satu
- Lofotrik : bila banyak flagellum disatu sisi
- Amfitrik : bila banyak flagellum dikedua ujung
- Peritrik : bila tersebar diseluruh permukaan sel bakteri

PERANAN BAKTERI
Dalam kehidupan manusia bakteri mempunyai peranan yang menguntungkan maupun yang merugikan.
Bakteri yang menguntungkan adalah sebagai berikut :
- Pembusukan (penguraian sisa-sisa mahluk hidup contohnya Escherichia colie).
- Pembuatan makanan dan minuman hasil fermentasi contohnya Acetobacter pada pembuatan asam cuka, Lactobacillus bulgaricus pada pembuatan yoghurt, Acetobacter xylinum pada pembuatan nata de coco dan Lactobacillus casei pada pembuatan keju yoghurt.
- Berperan dalam siklus nitrogen sebagai bakteri pengikat nitrogen yaitu Rhizobium leguminosarum yang hidup bersimbiosis dengan akar tanaman kacang-kacangan dan Azotobacter chlorococcum.
- Penyubur tanah contohnya Nitrosococcus dan Nitrosomonas yang berperan dalam proses nitrifikasi menghasilkan ion nitrat yang dibutuhkan tanaman.
- Penghasil antibiotik contohnya adalah Bacillus polymyxa (penghasil antibiotik polimiksin B untuk pengobatan infeksi bakteri gram negatif, Bacillus subtilis penghasil antibioti untuk pengobatan infeksi bakteri gram positif,Streptomyces griseus penghasil antibiotik streptomisin untuk pengobatan bakteri gram negatif termasuk bakteri penyebab TBC dan Streptomyces rimosus penghasil antibiotik terasiklin untuk berbagai bakteri.
- Pembuatan zat kimia misalnya aseton dan butanol oleh Clostridium acetobutylicum
- Berperan dalam proses pembusukan sampah dan kotoran hewan sehinggga menghasilkan energi alternatif metana berupa biogas. Contohnya methanobacterium
- Penelitian rekayasa genetika dalam berbagai bidang.sebagai contoh dalam bidang kedokteran dihasilkan obat-obatan dan produk kimia bermanfaat yang disintesis oleh bakteri, misalnya enzim, vitamin dan hormon.
Bakteri yang merugikan sebagai berikut :
- Pembusukan makanan contohnya Clostridium botulinum
- Penyebab penyakit pada manusia contohnya Mycobacterium tuberculosis ( penyebab penyakit TBC ), Vibrio cholerae ( penyebab kolera atau muntaber ), Clostridium tetani (penyebab penyakit tetanus ) dan Mycobacterium leprae (penyebab penyakit lepra )
- Penyebab penyakit pada hewan contohnya Bacilluc antrachis (penyebab penyakit antraks pada sapi )
- Penyebab penyakit pada tanaman budidaya contohnya Pseudomonas solanacearum (penyebab penyakit pada tanaman tomat, lombok, terung dan tembakau) serta Agrobacterium tumafaciens (penyebab tumor pada tumbuhan)
DAFTAR PUSTAKA
Dwidjoseputro, D.1998.Dasar-Dasar Mikrobiologi. Malang: Djambatan
Hadioetomo. 1988. Mikrobiologi Dasar Dalam Praktek. Jakarta: PT. Gramedia
Hidayati dkk. 2015. Bakteri. Ilmu gizi. STIKES Alma Ata Yogyakarta
Lay, Bibiana.W.1994.Analisis Mikroba di Laboratorium. Jakarta: Rajawali
Neelobon S., J. Burakorn, and S. Thaenthanee. 2007. Effect of culture Condition on Bacterial Celluloce (BC) production from Acetobacter xylium TISTR 976 and Phisical Properties of BC Parchment Paper. Bureau of Community Tecnology, Department of Science Servis, Ministy of Science and Technology. Bangkok
Oskar Adolfsson, Simin Nikbin Meydani, and Robert M Russell. 2004. Yogurt and gut function. Am J Clin Nutr August 2004 vol. 80 no. 2 245-256
Radji, maksum. 1955. Mikrobiologi Panduan Mahasiswa Farmasi dan Kedokteran. Jakarta: ECG
Rosihan, amha. 2015. (diakses 6 Maret 2016)
Suriawiria. 2002. Mikrobiologi Dasar dalam Praktek. Jakarta: PT. Garaemedia
Tryana, S.T. 2008. Dasar-Dasar Mikrobiologi. Malang: Djambatan
Waluyo, L. 2004. Mikrobiologi Umum. Malang : UMM Press.
Alcamo IE (2001). Fundamentals of microbiology. Boston: Jones and Bartlett. ISBN 0-7637-1067-9.
Atlas RM (1995). Principles of microbiology. St. Louis: Mosby. ISBN 0-8016-7790-4.
Martinko JM, Madigan MT (2005). Brock Biology of Microorganisms, 11th ed., Englewood Cliffs, N.J: Prentice Hall. ISBN 0-13-144329-1.
Holt JC, Bergey DH (1994). Bergey’s manual of determinative bacteriology, 9th ed., Baltimore: Williams & Wilkins. ISBN 0-683-00603-7.
Hugenholtz P, Goebel BM, Pace NR (1998). “Impact of culture-independent studies on the emerging phylogenetic view of bacterial diversity”. J Bacteriol 180 (18): 4765–74.
Funke BR, Tortora GJ, Case CL (2004). Microbiology: an introduction, 8th ed,, San Francisco: Benjamin Cummings. ISBN 0-8053-7614-3.
website Pelajaran SD SMP SMA dan Kuliah Terlengkap
mata pelajaran
jadwal mata pelajaran mata pelajaran sma jurusan ipa mata pelajaran sd mata pelajaran dalam bahasa jepang mata pelajaran kurikulum merdeka mata pelajaran dalam bahasa inggris mata pelajaran sma jurusan ips mata pelajaran sma
bahasa inggris mata pelajaran
bu ani memberikan tes ujian akhir mata pelajaran ipa
tujuan pemberian mata pelajaran pendidikan kewarganegaraan di sekolah adalah
dalam struktur kurikulum mata pelajaran mulok bersifat opsional. artinya mata pelajaran smp mata pelajaran ipa mata pelajaran bahasa indonesia mata pelajaran ips mata pelajaran bahasa inggris mata pelajaran sd kelas 1
data mengenai mata pelajaran favorit dikumpulkan melalui cara
soal semua mata pelajaran sd kelas 1 semester 2 mata pelajaran smk mata pelajaran kelas 1 sd mata pelajaran matematika mata pelajaran ujian sekolah sd 2022
bahasa arab mata pelajaran mata pelajaran jurusan ips mata pelajaran sd kelas 1 2021 mata pelajaran sbdp mata pelajaran kuliah mata pelajaran pkn
bahasa inggrisnya mata pelajaran mata pelajaran sma jurusan ipa kelas 10 mata pelajaran untuk span-ptkin mata pelajaran ppkn mata pelajaran ips sma mata pelajaran tik
nama nama mata pelajaran dalam bahasa inggris mata pelajaran pkn sd mata pelajaran mts mata pelajaran pjok
nama nama mata pelajaran dalam bahasa arab mata pelajaran bahasa inggrisnya mata pelajaran bahasa arab
seorang pengajar mata pelajaran akuntansi di sekolah berprofesi sebagai
nama mata pelajaran dalam bahasa jepang
hubungan bidang studi pendidikan kewarganegaraan dengan mata pelajaran lainnya
dalam struktur kurikulum mata pelajaran mulok bersifat opsional artinya mata pelajaran dalam bahasa arab
tujuan mata pelajaran seni rupa adalah agar siswa



